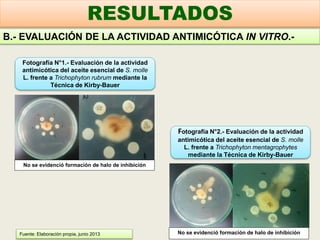
No se evidenció formación de halo de inhibición
No se evidenció formación de halo de inhibición
Fotografía N°1.- Evaluación de la actividad
antimicótica del aceite esencial de S. molle
L. frente a Trichophyton rubrum mediante la
Técnica de Kirby-Bauer
Fotografía N°2.- Evaluación de la actividad
antimicótica del aceite esencial de S. molle
L. frente a Trichophyton mentagrophytes
mediante la Técnica de Kirby-Bauer
B.- EVALUACIÓN DE LA ACTIVIDAD ANTIMICÓTICA IN VITRO.-
RESULTADOS
Fuente: Elaboración propia, junio 2013

Este documento presenta los resultados de un estudio que evaluó la actividad antimicótica in vitro del aceite esencial de las hojas de Schinus molle L. frente a Trichophyton rubrum y Trichophyton mentagrophytes. Se obtuvo un promedio de 11.4 mL de aceite esencial y se determinó que este tiene actividad antimicótica frente a ambos hongos mediante las técnicas de Kirby-Bauer y pozo en difusión. El estudio concluye que el aceite esencial de S. molle L. posee efecto